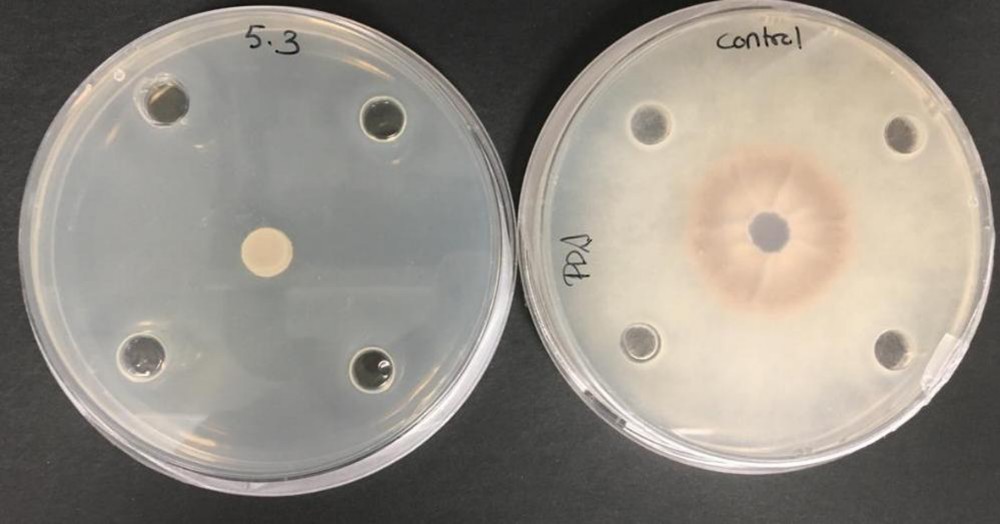

INAGROUP BIOTECH, en su firme objetivo por garantizar al agricultor los mejores productos a sus cultivos, ha desarrollado Fungitech. Se trata de un formulado de zinc (28 por ciento) químicamente estabilizado por ácidos carboxílicos. El zinc es un elemento tóxico para hongos ya que inhibe a proteínas esenciales de dichos microorganismos, bloqueando los sitios de unión de sus cofactores metálicos, eliminando así al hongo.

Fungitech es un formulado estabilizado por la tecnología de ácidos carboxílicos implantada en INAGROUP BIOTECH, S.L. Dicha tecnología permite estabilizar el zinc y ponerlo a disposición efectiva, además de permitir una mayor asimilación en la planta.
Asimismo, cabe destacar la enorme efectividad encontrada en los ensayos de laboratorio de esta firma, la cual se puede apreciar claramente a continuación.
Fungitech tiene un especial efecto sobre Phytophthora capsici “tristeza o seca del pimiento”, fusarium, oidio y cladosporium (fulvia) entre otros. Existe afinidad entre Fungitech y las estructuras móviles del patógeno en fases reproductivas, originando un efecto sistémico y una posterior toxicidad multisitio sobre el metabolismo del omiceto; su acción polivalente provoca la inhibición de la capacidad infectiva del hongo fitopatógeno a nivel de la zona radicular de la planta en aplicación a suelo y en aplicación aérea. En el caso de que se aplique a través de riego, se recomienda 2-5 kg/Ha, y si es vía foliar 1gr/L.
Respecto a su mecanismo y dinámica de actuación permite, además, lograr resultados de protección óptimos mediante aplicaciones preventivas en suelos con un historial marcado por la presencia de “tristeza” así como en momentos de especial susceptibilidad del cultivo a la infección por P. capsici, como pueden ser los fenómenos de encharcamiento del suelo del cultivo.
ÁCIDOS CARBOXÍLICOS
Si por algo se caracteriza INAGROUP BIOTECH es por estar “a la última”, ser vanguardistas, y no solo en el contenido, sino en el continente, adelantándose a las tendencias para poder perfeccionar los productos que luego acabarán en manos de los clientes. Así pues, esta tecnología basada en ácidos carboxílicos consiste en la selección y producción de nano moléculas con grupos carboxílicos, y dichas moléculas poseen un tamaño de 20-140.000 Dalton (Da).
Esta estructura química permite la estabilización de cationes metálicos como el Calcio, Magnesio, Potasio, Zinc, Hierro, Manganeso, Cobre y Cobalto, poniéndolos a mejor disposición para su asimilación en la planta.
BENEFICIOS
La aplicación de esta tecnología produce una mejora de la planta en situaciones de estrés y logra regular el pH del medio. Asimismo, se consigue mejorar la calidad del fruto y se incrementa la asimilación de nutrientes, aumentando también la disponibilidad en el tiempo de cationes. Además, esta tecnología basada en ácidos carboxílicos no deja residuos, es inocua, y se compone de moléculas naturales, por lo que cumple a la perfección con una de las señas de identidad de INAGROUP BIOTECH.
Todo el que desee conocer más acerca de cualquier producto de la amplia gama que ofrece INAGROUP BIOTECH S.L., puede consultar la página web http://inagroup.es/, visitando su sede en C/ Fontaneros, esquina con C/ Escayolistas, 04746 La Mojonera, Almería, llamando al +34 950 304 195 o mandando un correo a la dirección info@inagroup.es